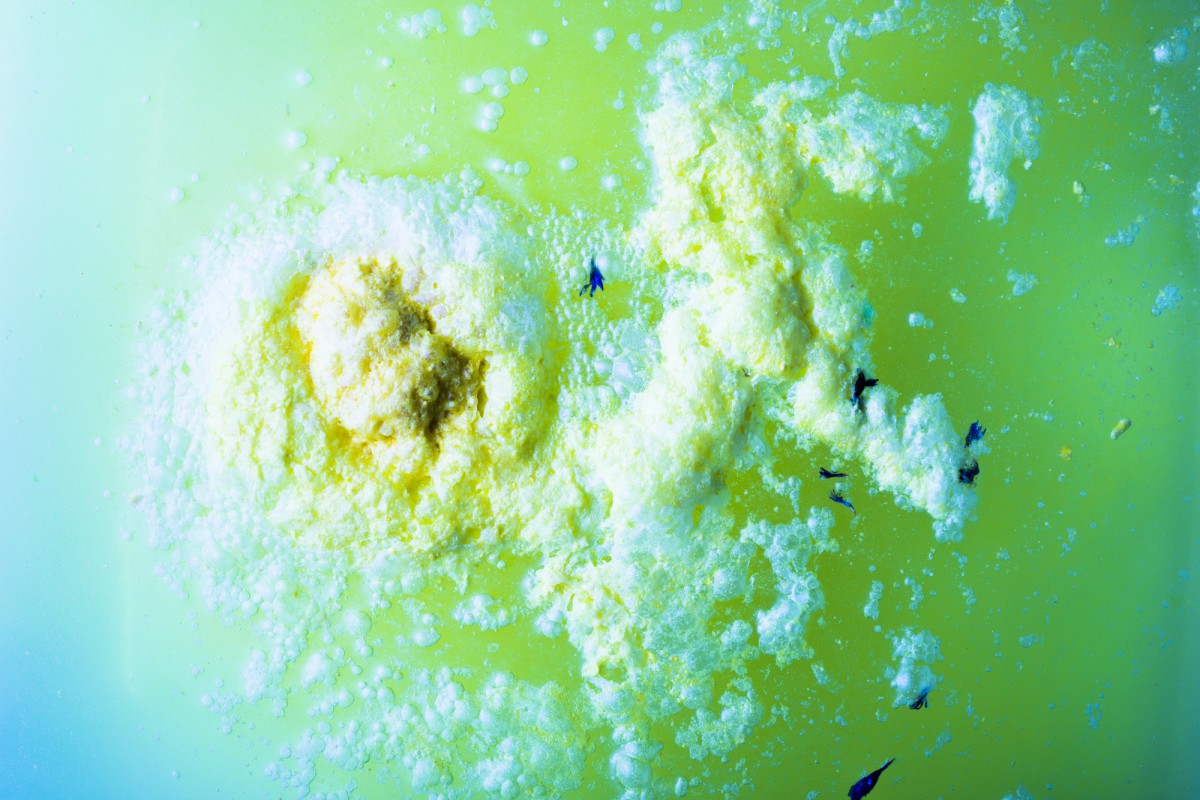
Как плесень в кондиционере может навредить здоровью

Снимаем макияж правильно: новая фишка с мицеллярной водой

Все девушки, кто снимает макияж при помощи мицеллярной воды, жалуются на то, как быстро уходит это средство. И в этом нет ничего удивительного, ведь обычно мы наносит мицеллярку на ватный диск, который быстро впитывает в себя жидкость. Теперь только представьте, сколько понадобится таких дисков, чтобы смыть сложный макияж и водостойкие средства. Как же экономно использовать средство для снятия косметики?
Своей находкой поделилась с подписчиками бьюти-блогер Татьяна Стрелова. Для того чтобы использовать мицеллярную воду по минимуму, перелейте ее в бутылочку с мягким распылителем. Теперь распределяем средство по всему лицу при помощи пшиков. Ждем около минуты, чтобы мицеллярка подействовала, после чего берем бумажную салфетку и снимаем макияж. Такой способ не только эффективнее очистит кожу от макияжа, но и сэкономит мицеллярную воду.
Многим девушкам понравился этот крутой совет. Теперь они пользуются средством для снятия макияжа только так.
«Не знаю, как я существовала без этого лайфхака раньше», «Очень удобно, и средство все на лице, а не на ватном диске», «Класс, мне понравился эффект», «Быстрый и очень крутой способ, советую», «Танечка, спасибо за твои советы, они помогают жить проще!», — поделились своими эмоциями от лайфхака пользовательницы Сети. / YouTube-канал "Tanya StreLove" .
- Лайфхак от Константина Нечетова: как правильно разогреть вчерашнюю пиццу?
- Совет от Марины Жуковой: как правильно стирать нижнее белье?
- Освежает не только дыхание: как правильно удалить жвачку с одежды?
- Лайфхак от Константина Нечетова: как правильно стирать грязные кухонные полотенца?
- Лайфхак от Любови Гончаровой: как оттереть пятна от воска с одежды?

Узнайте, почему магниты на холодильнике могут быть опасны для вашей техники и как это влияет на ваш бюджет.

Узнайте, как сохранить полезные свойства оливкового масла. Избегайте распространённых ошибок в хранении!
Узнайте, как плесень в кондиционере влияет на здоровье и почему регулярная чистка так важна.

Узнайте, почему магниты на холодильнике могут быть опасны для вашей техники и как это влияет на ваш бюджет.

Узнайте простой способ быстро освежить вялую морковь. Морковь станет хрустящей и аппетитной!

Узнайте, как сохранить полезные свойства оливкового масла. Избегайте распространённых ошибок в хранении!

Узнайте, как вернуть деньги за лишние товары в чеке. Простой способ от юриста.

Быстро и эффективно очищаем унитаз и ёршик: узнайте секрет!

Визажист рассказывает о сроках годности косметики и возможных рисках.

Узнайте, как ускорить зарядку вашего телефона с помощью одной простой хитрости. Экономьте время и энергию!

Узнайте, как распознать травмы после падения и предотвратить серьёзные последствия. Советы врача-травматолога.

Узнайте, в каких случаях невыплата кредита может привести к уголовной ответственности. Разбираем нюансы с экспертом.

Откройте для себя новый способ приготовления макарон! Узнайте, как бульон может преобразить их вкус и аромат.

Узнайте, почему важно избегать хранения червивых яблок в холодильнике. Опасный вредитель и угроза для продуктов.

Узнайте, как сделать кондиционер для белья из доступных ингредиентов. Мягкое и ароматное бельё без лишних трат!

Узнайте секретный приём приготовления капустного салата, который делали в советских столовых. Вкус из прошлого ждёт вас!

Узнайте простой способ очистки пульта дистанционного управления без вреда для электроники.

Узнайте секреты успешных покупок на новогодних распродажах и не переплатите за ненужные вещи.
